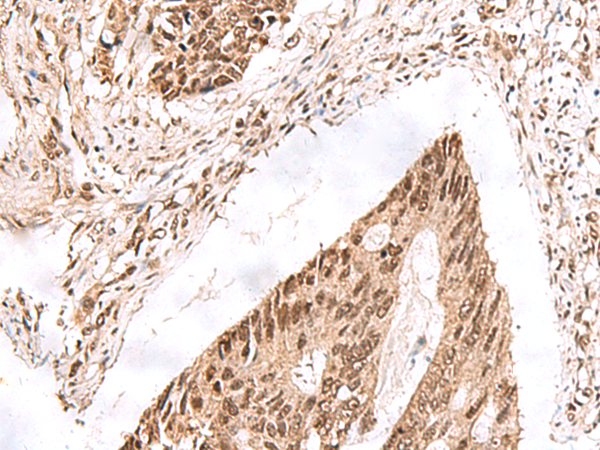

-
分类: 科研抗体货号: P13381别名: FAM154B应用: IHC反应种属: Human, Mouse
-
分类: 科研抗体货号: P13364别名: EXDL2; C14orf114应用: IHC反应种属: Human
-
分类: 科研抗体货号: P13375别名: MOB1D; C9orf35; MOBKL2B应用: WB反应种属: Human, Mouse
-
分类: 科研抗体货号: P13380别名: CANP; POIKTMP应用: IHC反应种属: Human
-
分类: 科研抗体货号: P13363别名:应用: IHC反应种属: Human
-
分类: 科研抗体货号: P13374别名: METT11D1应用: WB,IHC反应种属: Human, Mouse
-
分类: 科研抗体货号: P13379别名: CGI-67; C9orf77; FAM108B1应用: IHC反应种属: Human, Mouse, Rat
-
分类: 科研抗体货号: P13362别名: G9A; BAT8; GAT8; NG36; KMT1C; C6orf30应用: IHC反应种属: Human, Mouse
-
分类: 科研抗体货号: P13373别名: ODS1应用: WB反应种属: Human, Mouse
-
分类: 科研抗体货号: P13378别名: FXIIIB应用: IHC反应种属: Human

鄂公网安备42018502007531号
鄂公网安备42018502007531号

